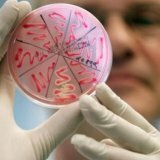
Иммуноферментный анализ и исследование болезней

Иммуноферментный анализ и исследование болезней
Иммуноферментный анализ и исследование болезней представляет собой вид лабораторного исследования, в основу которого положена иммунологическая реакция по типу «антиген-антитело». На сегодняшний день известно несколько десятков модификаций данного метода исследования.
Иммуноферментный анализ и исследование болезней представляет собой вид лабораторного исследования, в основу которого положена иммунологическая реакция по типу «антиген-антитело». На сегодняшний день известно несколько десятков модификаций данного метода исследования.
Своё название иммуноферментный анализ получил благодаря использованию ферментативной метки, которая вводится в один из компонентов иммунологической реакции. При взаимодействии специфического антитела с антигеном происходит активация фермента, и именно количество образованных продуктов цветной (ферментативной) реакции, определяемое по интенсивности их окрашивания, позволяет оценить количество антигенов или антител во взятом для исследования материале. Таким образом, иммуноферментный анализ позволяет провести качественную и количественную диагностику определённой инфекции.
В последнее время популярность иммуноферментного анализа существенно выросла, что объясняется высокой специфичностью и разнообразием используемых тест-систем. Для данного вида исследования в качестве материала используется плазма или сыворотка венозной крови, забор которой производится натощак. Чаще всего иммуноферментный анализ применяется для выявления в крови антител, которые вырабатываются иммунной системой человека в ответ на попадание в организм антигенов возбудителей различных заболеваний. Однако при помощи данного метода исследования можно выявлять и антигены возбудителей всевозможных инфекции в данной биологической жидкости.
В современной медицине метод иммуноферментного анализа болезней используется для диагностики различных заболеваний вирусной и бактериальной природы, для выявления аутоантител, определения уровня гормонов и для нахождения маркеров онкопатологии. На сегодняшний день специфичность и чувствительность данного лабораторного метода оценивается как минимум в 10%. Специфичность некоторых современных тест-систем иммуноферментного анализа, в частности тест-систем рекомбинантного типа, стабильно приближается к 100%. Следует отметить, что выявление методом иммуноферментного анализа антигена возбудителя того или иного заболевания, в отличие от вирусологических и бактериологических методов исследования, не зависит от его жизнеспособности. То есть антигены будут найдены при помощи тест-систем ИФА и в том случае, если возбудитель продолжает свою жизнедеятельность, и тогда, когда в результате лечения или за счёт внутренних резервов организма возбудитель был обезврежен.
Вместе с тем отрицательный результат при выявлении антител к антигенам возбудителя той или иной инфекции и болезней не может быть гарантией того, что человек здоров, так как иммунный ответ формируется в течение определённого времени, что и определяет рекомендации проводить иммуноферментный анализ в динамике, как минимум дважды через временной промежуток, составляющий 2-3 недели. Нельзя забывать и о том, что возможны ситуации получения ложноотрицательных и ложноположительных результатов, поскольку выявление иммуноглобулинов свидетельствует о наличии антител к возбудителю заболевания, а не о присутствии в организме самого возбудителя. Посредством специальных тест-систем иммуноферментного анализа можно выявлять как антитела, относящиеся к различным классам иммуноглобулинов, так и проводить количественный анализ иммуноглобулинов определённого класса. Используя тест-системы, позволяющие выявлять иммуноглобулины, относящиеся к различным классам, можно с высокой вероятностью судить о стадии инфекционного процесса, поскольку иммуноглобулины вырабатываются организмом человека в строго предопределённой последовательности.
Иммуноглобулины, относящиеся к классу М, вырабатываются иммунной системой человека раньше всех при инфицировании, но их уровень быстро снижается при элиминации возбудителя. Совершенно иначе ведут себя иммуноглобулины, принадлежащие к классу G. Они вырабатываются значительно позже при инфицировании, но циркулируют в организме человека и после выздоровления. Особое внимание уделяется в ходе иммуноферментного анализа иммуноглобулину класса А, а также его соотношению с иммуноглобулинами, принадлежащими к классам М и G. Предположить повторное заражение можно при высоких концентрациях иммуноглобулинов А и М, а о переходе острого процесса в хронический свидетельствуют повышенные титры иммуноглобулинов G и А. Таким образом, выявление иммуноглобулинов определённого класса позволяет оценить динамику инфекционного процесса. Как и любой другой метод лабораторной диагностики, иммуноферментный анализ имеет свои достоинства и недостатки.
Среди неоспоримых преимуществ данного метода диагностики болезней широкий спектр выявляемых с его помощью инфекций, быстрота проведения лабораторного исследования; относительная простота методики; возможность осуществления объективной оценки, силы иммунного ответа организма на антигены возбудителя, установление фазы инфекционного процесса, отслеживание динамики иммунного ответа. Серьёзным недостатком иммуноферментного анализа является определение иммунной реакции человеческого организма на возбудителя инфекционного заболевания, а не выявление собственно самого возбудителя, в результате чего ИФА отнесён к непрямым диагностическим методам.